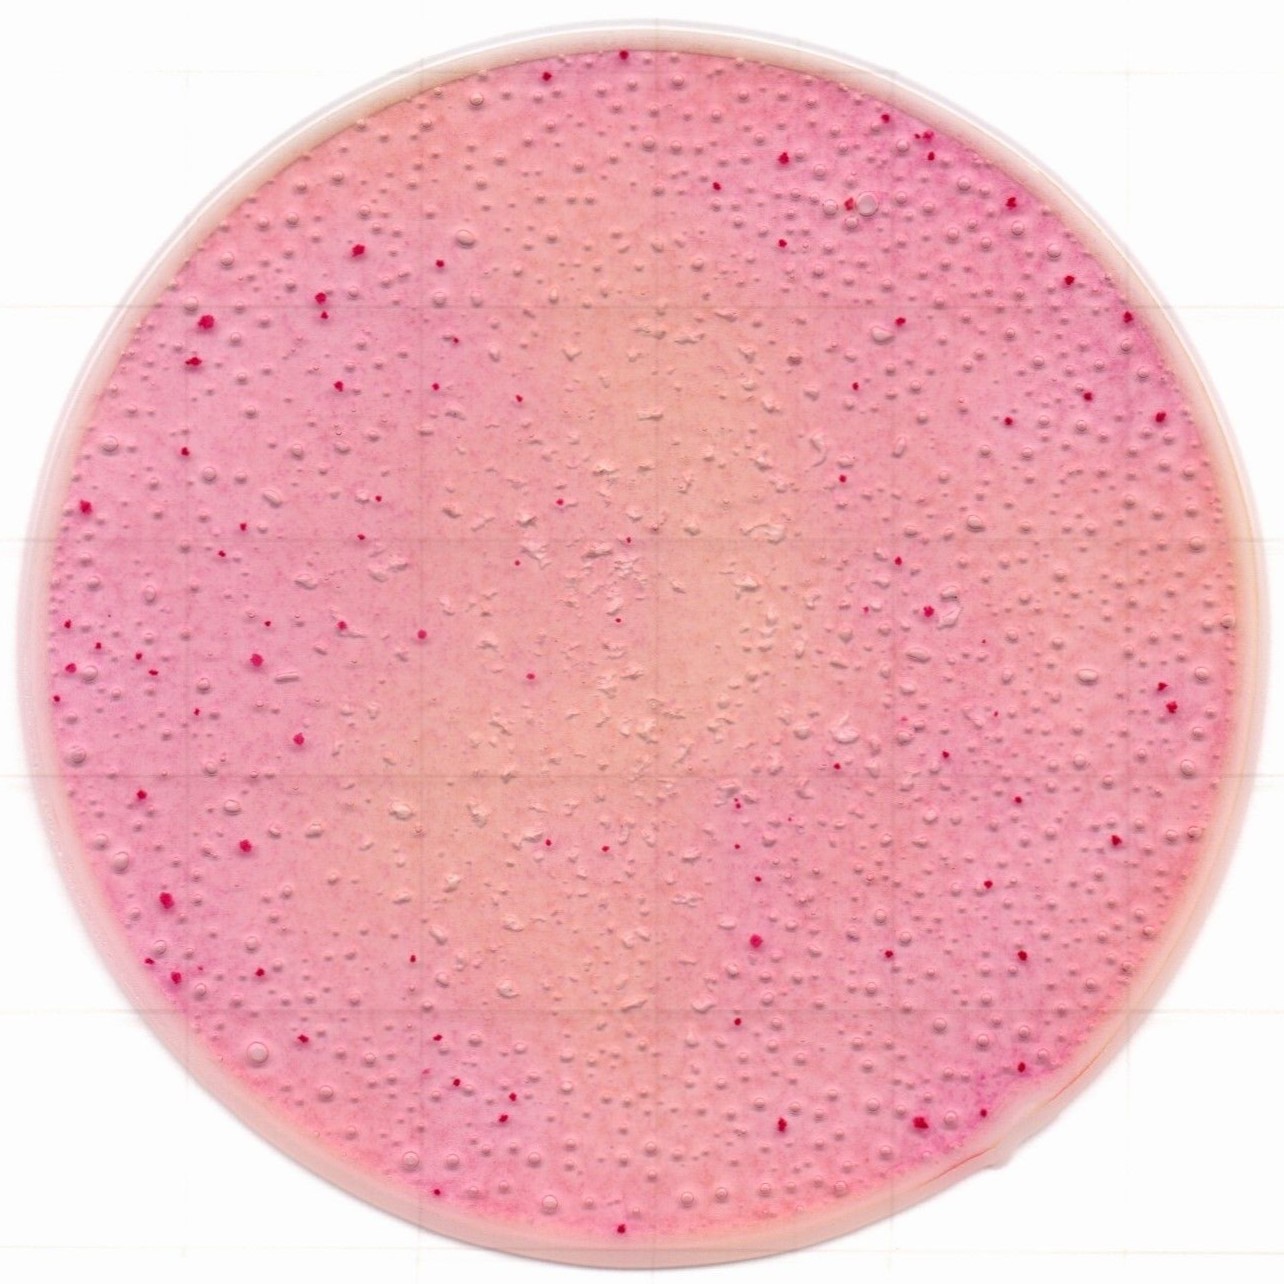
1217129075822598.jpg 1217129075822598.jpg
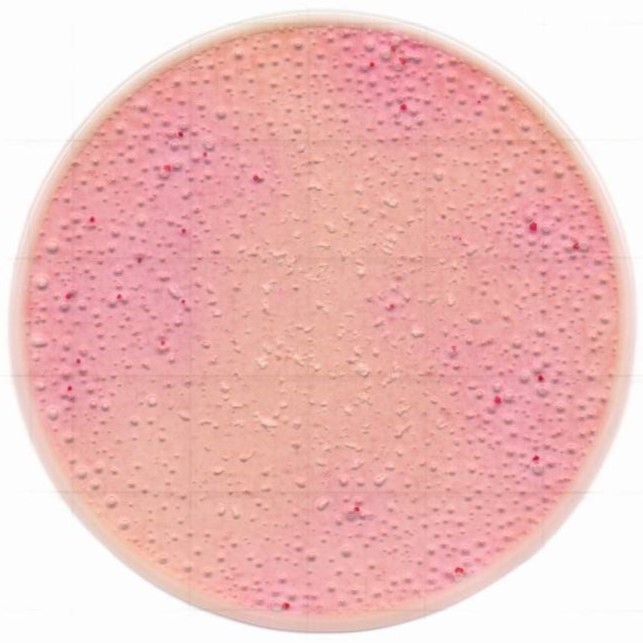
1217129076179898.jpg 1217129076179898.jpg
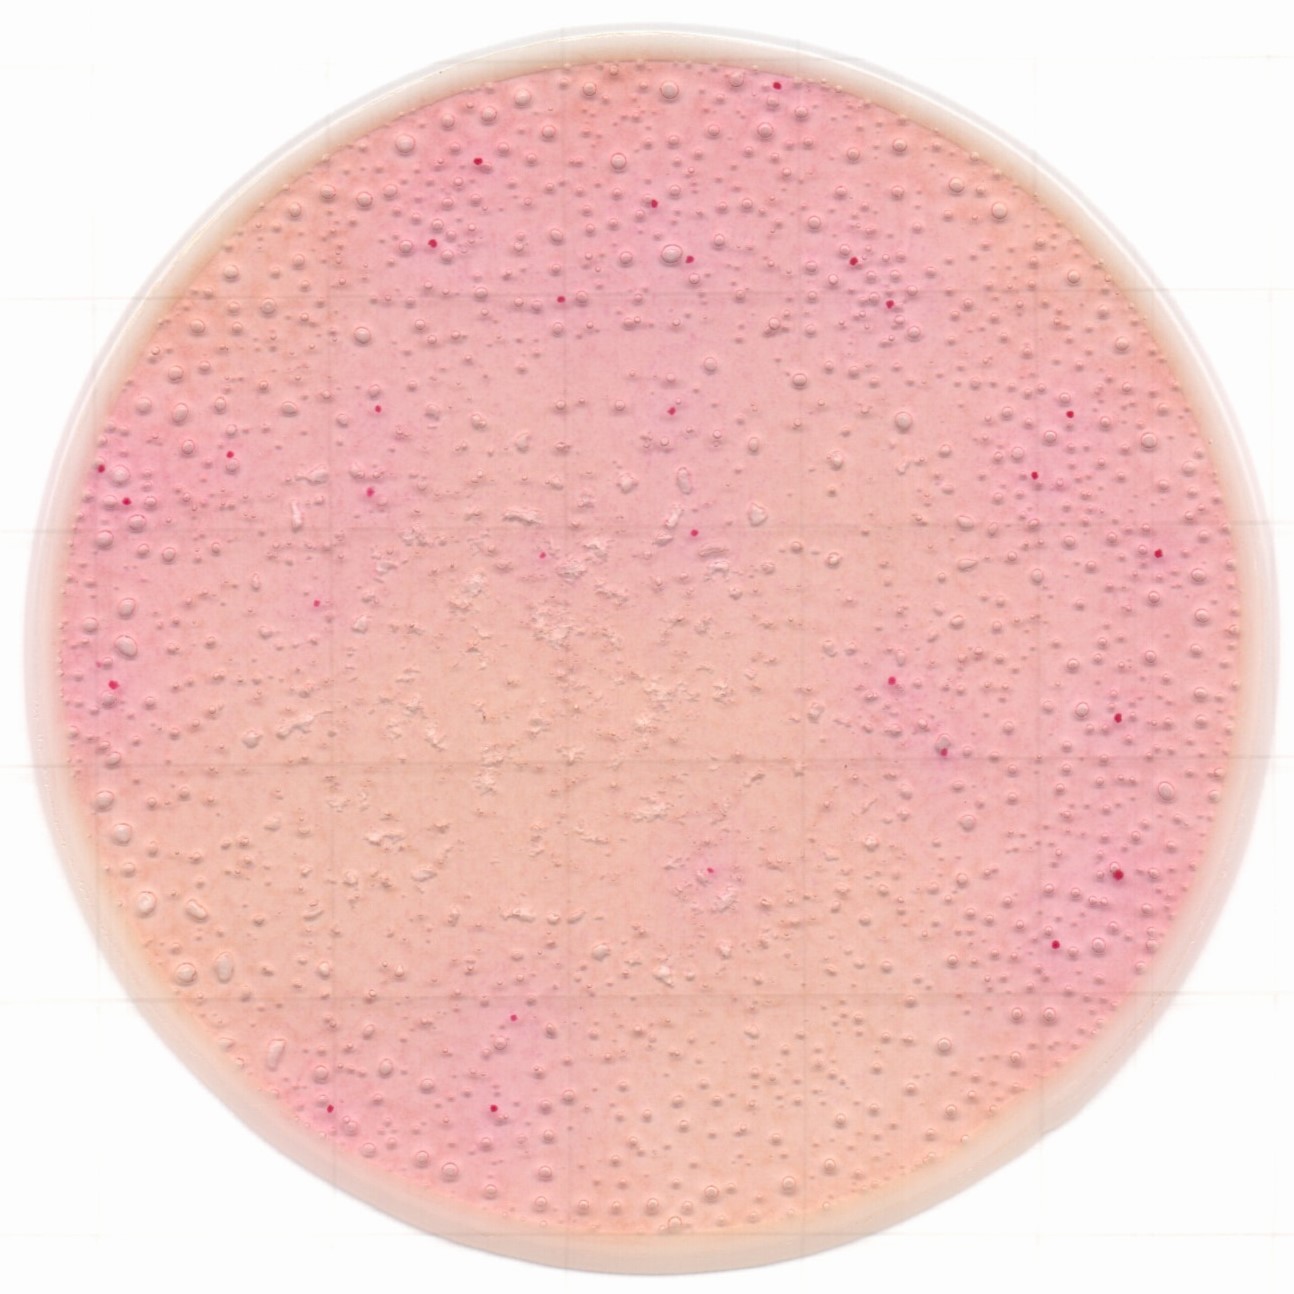
1217129076531939.jpg 1217129076531939.jpg
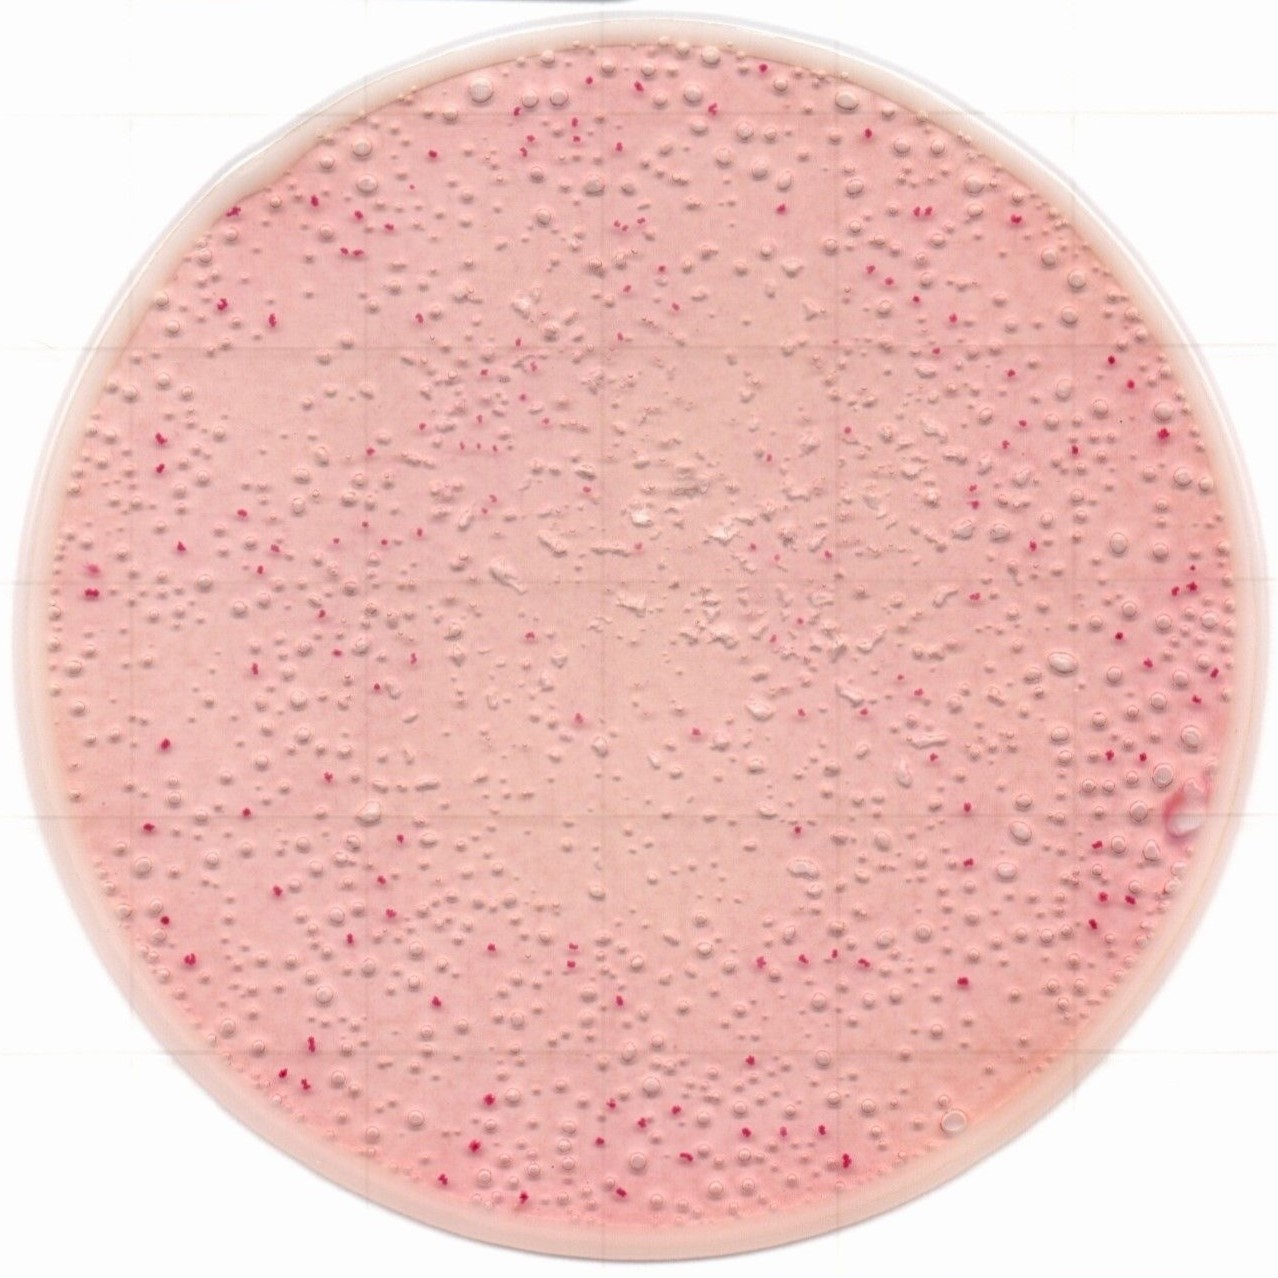
1217129076693198.jpg 1217129076693198.jpg

相关产品推荐更多 >
万千商家帮你免费找货
0 人在求购买到急需产品
- 详细信息
- 技术资料
肠杆菌科检测用测试片
Easy Plate™ EB
![]()
![]() |
肠杆菌科薄膜培养基测试片,检测原理与VRBG琼脂培养基相同,菌落呈红紫~红色。 判读简单,仅目标菌落会显色,无需确认有无气泡以及菌落大小。 |
◆特点
菌落24小时即可清晰显色
菌落呈红紫~紫色,即使存在食物残渣,也能轻松识别和计数。无需确认有无气泡以及菌落大小。

与琼脂培养基的结果高度相关
经确认与VRBG琼脂培养基相关性高,适用于各种食物的检测。

◆显色示例
请通过稀释调整菌落数至合适的测量范围内,合适的测量范围为1~250 CFU/mL。
※以下显色示例仅供参考。
※培养条件:35℃、24 h
菌株
|
Klebsiella pneumoniae (NBRC 14940) |
Escherichia coli (NBRC 15034) |
Salmonella enterica subsp.enterica (NBRC 13245) |
![]() |
![]() |
![]() |
食品
|
猪肉 94 CFU/mL |
牛肉 159 CFU/mL |
马肉 29 CFU/mL |
![]() |
![]() |
![]() |
|
芝士 52 CFU/mL |
樱桃 31 CFU/mL |
葱 151 CFU/mL |
![]() |
![]() |
![]() |
产品信息
|
产品编号 |
61978 |
|
产品名称 |
Easy Plate EB 肠杆菌科快速检测用 |
|
包装 |
100片(25片×4包) |
|
微生物检测对象 |
肠杆菌科 |
|
培养时间 |
24±1小时 |
|
培养温度 |
35±1℃或37±1℃ |
|
保存条件(未开封) |
2-8℃ |
| 保存条件(开封后) | 开封后,将包装的开口端至少折叠2次并用胶带固定。存放在冰箱(2-8°C)中,并在3个月内使用。 |
|
有效期 |
自生产后12个月 |
|
检测次数 |
100次 |
点击此处查看相关产品详情
风险提示:丁香通仅作为第三方平台,为商家信息发布提供平台空间。用户咨询产品时请注意保护个人信息及财产安全,合理判断,谨慎选购商品,商家和用户对交易行为负责。对于医疗器械类产品,请先查证核实企业经营资质和医疗器械产品注册证情况。
技术资料暂无技术资料 索取技术资料